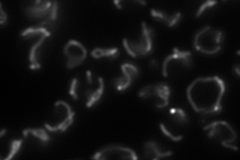
YLL041C
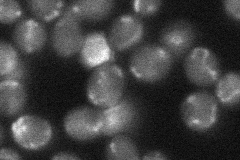
YLL041C

View description
Iron-sulfur protein subunit of succinate dehydrogenase (Sdh1p, Sdh2p, Sdh3p, Sdh4p), which couples the oxidation of succinate to the transfer of electrons to ubiquinone
Localization:
Intensity:
Fold change:
Significance:
-
C’ GFP library in SD

mitochondria93.68 -
N' NOP1pr-GFP in SD
mitochondria100.944 -
N' TEF2pr-mCherry in SD

punctate,mitochondria7.0483 -
N' NATIVEpr-GFP in SD
mitochondria28.7134 -
N' TEF2pr-VC and Cyto-VN in SD

#N/A0 -
C’ GFP library in SD+DTT

mitochondria94.31No -
C’ GFP library in SD+H2O2

vacuole membrane73.520.78No -
C’ GFP library in Starvation Media

mitochondria177.81.89Yes -
C’ GFP library on the background of Pup2-DaMP

mitochondria -
C’ GFP library on the background of CCT mutant

mitochondria57.58410.614667Yes
